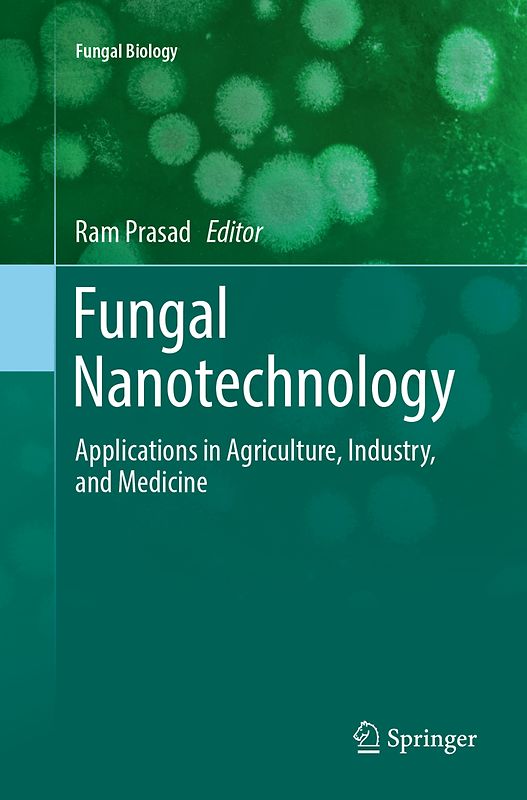
Fungal Nanotechnology

iPhoneAlle anzeigen
iPhone 11iPhone 11 ProiPhone 11 Pro MaxiPhone 12iPhone 12 ProiPhone 12 Pro MaxiPhone 12 miniiPhone 13iPhone 13 ProiPhone 13 Pro MaxiPhone 13 miniiPhone 14iPhone 14 PlusiPhone 14 ProiPhone 14 Pro MaxiPhone 15iPhone 15 PlusiPhone 15 ProiPhone 15 Pro MaxiPhone 16iPhone 16 PlusiPhone 16 ProiPhone 16 Pro MaxiPhone 16eiPhone 8iPhone 8 PlusiPhone SE 2020iPhone SE 2022iPhone XiPhone XRiPhone XSiPhone XS Max
Galaxy A-SerieAlle anzeigen
Galaxy A12Galaxy A13Galaxy A13 5GGalaxy A14Galaxy A15Galaxy A16Galaxy A17 5GGalaxy A20eGalaxy A21Galaxy A22Galaxy A23Galaxy A24Galaxy A25Galaxy A26 5GGalaxy A32Galaxy A33Galaxy A34Galaxy A35Galaxy A36 5GGalaxy A40Galaxy A41Galaxy A42Galaxy A50Galaxy A51Galaxy A52Galaxy A53Galaxy A54Galaxy A55Galaxy A56 5GGalaxy A70Galaxy A71Galaxy A72
Redmi SeriesAlle anzeigen
Redmi 10Redmi 13CRedmi 15 5GRedmi Note 10Redmi Note 10 ProRedmi Note 11Redmi Note 11 ProRedmi Note 11 Pro Plus 5GRedmi Note 11sRedmi Note 12Redmi Note 12 5GRedmi Note 12 ProRedmi Note 12 Pro 5GRedmi Note 12 Pro PlusRedmi Note 13Redmi Note 13 5GRedmi Note 13 ProRedmi Note 13 Pro PlusRedmi Note 14Redmi Note 14 Pro PlusRedmi Note 8Redmi Note 8 ProRedmi Note 9Redmi Note 9 Pro
Derzeit nicht verfügbar
Handgeprüfte Gebrauchtware
Bis zu 50 % günstiger als neu
Der Umwelt zuliebe
Optischer Zustand
Beschreibung
Fungal nanotechnology has great prospects for developing new products with industrial, agricultural, medicinal, and consumer applications in a wide range of sectors. The fields of chemical engineering, agri-food, biochemistry, pharmaceuticals, diagnostics, and medical device development all employ fungal products, with fungal nanomaterials currently used in applications ranging from drug… development to the food industry and agricultural biotechnology. Fungal agents are an environmentally friendly, clean, non‐toxic agent for the synthesis of metal nanoparticles and employ both intracellular and extracellular methods. The simplicity of scaling up and downstream processing and the presence of fungal mycelia which afford an increased surface area provide key advantages. In addition, the large spectrum of synthesized nanoparticle morphologies and the substantially faster biosynthesis rate in cell-free filtrate (due to the higher amount of proteins secreted in fungi) make this a particularlyenticing route. Understanding the diversity of fungi in assorted ecosystems, as well as their interactions with other microorganisms, animals, and plants, underpins real and innovative technological developments and the applications of metal nanoparticles in many disciplines including agriculture, catalysis, and biomedical biosensors. Importantly, biogenic fungal nanoparticles show significant synergistic characteristics when combined with antibiotics and fungicides to offer substantially greater resistance to microbial growth and applications in nanomedicine ranging from topical ointments and bandages for wound healing to coated stents. Dieses Produkt haben wir gerade leider nicht auf Lager.
Handgeprüfte Gebrauchtware
Bis zu 50 % günstiger als neu
Der Umwelt zuliebe
Technische Daten
Erscheinungsdatum
09.09.2018
Sprache
Englisch
EAN
9783319886015
Herausgeber
Springer International Publishing
Serien- oder Bandtitel
Fungal Biology
Sonderedition
Nein
Seitenanzahl
295
Auflage
1
Einbandart
Broschiert
Buch Untertitel
Applications in Agriculture, Industry, and Medicine
Hersteller: Springer, Europaplatz 3, Heidelberg, Deutschland, 69115, ProductSafety@springernature.com, Springer Nature Customer Service Center GmbH
-.-
★★★★★
☆☆☆☆☆ Leider noch keine Bewertungen
Leider noch keine Bewertungen
Sicher bei rebuy kaufen
Schreib die erste Bewertung für dieses Produkt!
Wenn du eine Bewertung für dieses Produkt schreibst, hilfst du allen Kund:innen, die noch überlegen, ob sie das Produkt kaufen wollen. Vielen Dank, dass du mitmachst!
Sicher bei rebuy kaufen

